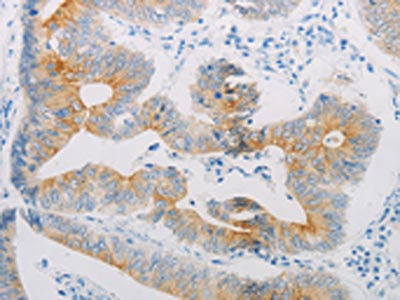

ADRB2 Antibody
-
中文名稱(chēng):ADRB2兔多克隆抗體
-
貨號(hào):CSB-PA211297
-
規(guī)格:¥1100
-
圖片:
-
The image on the left is immunohistochemistry of paraffin-embedded Human liver cancer tissue using CSB-PA211297(ADRB2 Antibody) at dilution 1/20, on the right is treated with synthetic peptide. (Original magnification: ×200)
-
The image on the left is immunohistochemistry of paraffin-embedded Human colon cancer tissue using CSB-PA211297(ADRB2 Antibody) at dilution 1/20, on the right is treated with synthetic peptide. (Original magnification: ×200)
-
Gel: 10%SDS-PAGE, Lysate: 30 μg, Lane 1-2: Hela cells, A549 cells, Primary antibody: CSB-PA211297(ADRB2 Antibody) at dilution 1/600, Secondary antibody: Goat anti rabbit IgG at 1/8000 dilution, Exposure time: 1 minute
-
-
其他:
產(chǎn)品詳情
-
Uniprot No.:
-
基因名:
-
別名:ADRB2; ADRB2R; B2AR; Beta-2 adrenergic receptor; Beta-2 adrenoreceptor; Beta-2 adrenoceptor
-
宿主:Rabbit
-
反應(yīng)種屬:Human,Mouse
-
免疫原:Synthetic peptide of Human ADRB2
-
免疫原種屬:Homo sapiens (Human)
-
標(biāo)記方式:Non-conjugated
-
抗體亞型:IgG
-
純化方式:Antigen affinity purification
-
濃度:It differs from different batches. Please contact us to confirm it.
-
保存緩沖液:-20°C, pH7.4 PBS, 0.05% NaN3, 40% Glycerol
-
產(chǎn)品提供形式:Liquid
-
應(yīng)用范圍:ELISA,WB,IHC
-
推薦稀釋比:
Application Recommended Dilution ELISA 1:1000-1:2000 WB 1:1000-1:2000 IHC 1:15-1:50 -
Protocols:
-
儲(chǔ)存條件:Upon receipt, store at -20°C or -80°C. Avoid repeated freeze.
-
貨期:Basically, we can dispatch the products out in 1-3 working days after receiving your orders. Delivery time maybe differs from different purchasing way or location, please kindly consult your local distributors for specific delivery time.
-
用途:For Research Use Only. Not for use in diagnostic or therapeutic procedures.
相關(guān)產(chǎn)品
靶點(diǎn)詳情
-
功能:Beta-adrenergic receptors mediate the catecholamine-induced activation of adenylate cyclase through the action of G proteins. The beta-2-adrenergic receptor binds epinephrine with an approximately 30-fold greater affinity than it does norepinephrine.
-
基因功能參考文獻(xiàn):
- CD147 and the beta2-adrenergic receptor form hetero-oligomeric complexes. PMID: 28569760
- The authors suggest that increased circulating beta2-adrenergic receptor autoantibodies are associated with smoking-related emphysema. PMID: 28262783
- Phosphopeptide ligation onto the beta2-adrenergic receptor (beta2AR) allows stabilization of a high-affinity receptor active state by beta-arrestin1. PMID: 29581292
- This study provided proof that SNPs within ADRB2 is significantly associated with the susceptibility to and the prognosis of cervical vertigo, so that NPY and NA might serve as the precise diagnostic marker and treatment target of cervical vertigo. PMID: 29197114
- A functional SNP (rs12654778), upstream of ADRB2, was significantly associated with increased risk for COPD. PMID: 29588580
- Data indicate clustering of beta-2 adrenergic receptor (beta2AR) variants based on their signaling profiles. PMID: 29255305
- We found that polymorphic Arg16Gly in the ADRB2 gene and Ala54Thr in the FABP2 gene had a discernible effect on the renal function in Chinese type 2 DN. Our data further revealed that homozygous Gly16 allele and Thr54 allele concomitantly conferred a significantly higher risk in the eGFR reduction. PMID: 29404926
- decreased beta2AR functionality in patients with OA and LC was independent of patient's beta2AR genotype. PMID: 29620176
- there was no change in beta2-AR expression in the muscular layer of the dilated ureter PMID: 28756611
- Phosphorylation of the C-terminal region of ADRB2 allosterically alters the conformation around M215(5.54) and M279(6.41), located on transemembrane helices 5 and 6. PMID: 29335412
- Downregulation of the expression of DUSP1 or protein phosphatase 1 led to a decline in the beta2adrenergic receptormediated dephosphorylation of ERK1/2. PMID: 29257221
- In vitro studies confirmed that activation of b2AR can promote epithelial mesenchymal transition in Tongue squamous cell carcinoma (TSCC) by initiating an interleukin6/Stat3/Snail1 pathway. These results suggest that b2AR has an oncogenic role in TSCC and may be a potential therapeutic target in TSCC. PMID: 29138797
- Study analyzed dynamic behavior of 16 important residues in the binding pockets of beta2-adrenergic receptor bound with a variety of ligands, among which D1133.32 and N3127.39 are essential for ligand binding. The polar interactions with residues in TM5, particularly S2035.42 and S2075.46, are related to the agonistic properties, whereas hydrophobic interactions with residues in TM5 and TM6 help stabilize the receptor. PMID: 27703221
- SNPs at codon 16 of the ADRB2 plays a role in the oxidative metabolic demand during exercise. PMID: 29061864
- The presence of polymorphisms associated with the Glu27 allele and Arg16Gly and Gln27Glu genotypes had no influence on exercise-induced bronchospasm. However, the statistical trend towards greater frequency of the Gly16 allele in individuals with exercise-induced bronchospasm can be considered evidence of the influence of polymorphisms of the ADBR2 gene on EIB in adolescents. PMID: 26684442
- The association of Arg16 allele with the occurrence of asthma and of the Glu27 allele with overweight asthmatic adolescents evidenced the contribution of the ADBR2 gene to the development of obesity and asthma. PMID: 26409918
- These data highlight a novel arrestin-mediated modulation of CREB signalling, suggesting a reciprocal relationship between arrestin2 and arrestin3, wherein recruitment of arrestin3 restricts the ability of beta2AR to activate prolonged CREB phosphorylation by precluding recruitment of an arrestin2/Src/p38 complex. PMID: 28733084
- This systematic review and meta-analyses found that COPD risk and response to inhaled beta2-agonists were not associated with Thr164Ile, Arg16Gly, and Gln27Glu genotypes. PMID: 28506092
- The discovery of B2AR as a new molecular marker of obesity subphenotypes in PBMCs might contribute to clarify the adrenergic immunomodulation of inflammatory obesity. PMID: 28824322
- Genotypes at two variants of ADRB2 are associated with IAH. This association is comparable with the risk of classical risk factors for hypoglycemia . PMID: 28692628
- beta2AR signaled through Galphas and Gbetagamma subunits through a pathway that involved the tyrosine kinase SRC, the adaptor protein SHC, the guanine nucleotide exchange factor SOS, the small GTPase RAS, and the kinases RAF and MEK, which led to ERK activation PMID: 28634209
- these results indicate that stimulation of the beta2AR in osteoblasts triggers a Vegf-dependent neo-angiogenic switch that promotes bone vascular density and the colonization of the bone microenvironment by metastatic breast cancer cells. PMID: 28300321
- beta2AR is linked to transcription of alpha-synuclein and risk of Parkinson's disease in a ligand-specific fashion and constitutes a potential target for therapies. PMID: 28860381
- Lifetime ovulatory years were more strongly associated with ADRB2-positive ovarian tumors compared with ADRB2-negative tumors. Significant heterogeneity by ADRB2 was also observed for parity, oral contraceptive use, and age at menopause. Tumor expression of ADRB2 was not associated with ovarian cancer mortality. PMID: 27587791
- ADRB2 gene polymorphism is associated with bronchodilator response in chronic obstructive pulmonary disease. PMID: 28327457
- These data suggest that genetic variation of the ADRB2 may influence relative strength in healthy subjects and may become an important genetic determinant of muscular strength and functional capacity PMID: 28557859
- Findings support a supramultiplicative interaction between the Gln27Glu ADRB2 variant and socioeconomic deprivation among individuals of European descent. PMID: 27153462
- ADRB2 gene expressed in HIV-associated neurocognitive impairment and encephalitis chaperones OPRM1, normally located intracellularly in astrocytes, to the cell surface. PMID: 27400929
- X ray structure of the beta2AR bound to a polyethylene glycol-carboxylic acid derivative (Cmpd-15PA) PMID: 28813418
- This study demonstrates that adverse drug events induced by ritodrine are associated with ADRB2 gene polymorphisms, as well as the infusion rate of ritodrine in pregnant women with preterm labor. PMID: 29132297
- The association was reported between rs1042713 and rs1042714 polymorphisms in ADRB2 gene and tuberculosis for the first time. rs1042713*G and rs1042714*G polymorphisms in ADRB2 gene makes people more susceptible to develop the disease. PMID: 27900465
- a substantial proportion of the beta2AR produced is non-functional and VCP plays a key role in the maturation and trafficking of the beta2AR. PMID: 27887991
- The protein kinase activity of PI3K phosphorylates serine residue 70 on Src to enhance its activity and induce EGFR transactivation following betaAR stimulation. PMID: 27169346
- The data suggested that Arg/Arg homozygosity at codon 16 of the ADRB2 gene predisposes patients to a clinically more severe course of chronic obstructive pulmonary disease PMID: 28093224
- using single-molecule fluorescence resonance energy transfer imaging, we examine TM6 movements in the beta2 adrenergic receptor (beta2AR) upon exposure to orthosteric ligands with different efficacies, in the absence and presence of the Gs heterotrimer PMID: 28607487
- Data show that both N6Q and N15Q mutations decreased receptor dimerization, while N187Q mutation did not influence receptor dimerization. PMID: 28467637
- The frequency of the genotypes and alleles of rs1042711 in ADRB2 showed a significant difference between the COPD and control groups. TT genotype and TG and TC haplotypes of rs1042711 in ADRB2 are related to pulmonary function in COPD patients. TT genotype of rs1042711 in ADRB2 and smoking amount are risk factors for COPD development. PMID: 28753063
- Results provide further evidence for the interaction of rs2400707, and other SNPs within the ADRB2 gene, with childhood trauma in relation to risk for posttraumatic stress disorder. PMID: 27701011
- Gln27Glu polymorphism of ADRB2 influences exercise-induced vascular adaptation in patients with acute coronary syndrome. PMID: 28235084
- B2A receptors play an important role in colorectal carcinogenesis and can be utilized as prognostic factors PMID: 28275305
- beta2-adrenoceptor gly16gly genotype is associated with the elevated resting cardiac output during anesthesia for abdominal aortic aneurysm surgery. PMID: 27632347
- Data suggest that ADRB2 (beta2 adrenergic receptor) activation (as illustrated by epinephrine and nor epinephrine) leads to robust calcium ion mobilization from intracellular stores in endoplasmic reticulum via activation of phosphoinositide phospholipase C (PLC) and opening of inositol trisphosphate receptor (IP3R). PMID: 28442571
- Data suggest that post-translational modifications (phosphorylation, oxidation, and nitrosylation) of RyR2 (ryanodine receptor 2) occur downstream of production of amyloid beta-peptides through ADRB2 (beta2-adrenergic receptor) Ca2+ signaling cascade that activates PKA (protein kinase A). PMID: 28476886
- The use of a LABA but not an LTRA as an "add-on controller" is associated with increased risk of asthma exacerbation in children carrying 1 or 2 A alleles at rs1042713. PMID: 26774659
- ADRB2 SNPs might be a genetic risk factor for dyslipidemia in the Chinese hypertensive patients. the A46G polymorphism was significantly associated with the elevated risk of hypertriglyceridemia. Haplotype analysis showed that the TAC haplotype carrying frequent alleles of the three SNPs played a reduced role in hypertriglyceridemia risk and the TGC haplotype carrying rare allele of A46G expressed a significant risk effe PMID: 28287890
- The beta2-adrenergic receptor, which induces a short cAMP response, prolongs nuclear cAMP and protein kinase A (PKA) activation by promoting endosomal cAMP production in parathyroid hormone (PTH) receptor signaling through the stimulatory action of G protein Gbetagamma subunits on adenylate cyclase type 2. PMID: 28024151
- beta2AR S-palmitoylated at Cys-265 are selectively preserved under a sustained adrenergic stimulation, which results in the down-regulation and degradation of betaAR. PMID: 27481942
- The Galphas and Galphaq peptides adopt different orientations in beta2-AR and V1AR, respectively. The beta2-AR/Galphas peptide interface is dominated by electrostatic interactions, whereas the V1AR/Galphaq peptide interactions are predominantly hydrophobic. PMID: 27330078
- Thus the beta2AR acts as a double-edged sword: increasing TAS2R14 cell surface expression, but when activated by beta-agonist, partially offsetting the expression phenotype by direct receptor:receptor desensitization of TAS2R14 function. PMID: 27342779
- In this study we determined the relationship between the ADRB2 Arg16Gly polymorphism and GSTP1 polymorphisms, involved in bronchodilator response and oxidative stress, respectively, with susceptibility to asthma. The ADRB2 genotype frequencies of the patients and control cases were found to be 10.9% (Arg16Arg), 48.8% (Arg16Gly), and 40.3% (Gly16Gly) and 24.4% (Arg16Arg), 36.2% (Arg16Gly), and 39.4% (Gly16Gly), respective PMID: 27385593
顯示更多
收起更多
-
亞細(xì)胞定位:Cell membrane; Multi-pass membrane protein. Early endosome. Golgi apparatus.
-
蛋白家族:G-protein coupled receptor 1 family, Adrenergic receptor subfamily, ADRB2 sub-subfamily
-
數(shù)據(jù)庫(kù)鏈接:
Most popular with customers
-
-
Phospho-YAP1 (S127) Recombinant Monoclonal Antibody
Applications: ELISA, WB, IHC
Species Reactivity: Human
-
-
-
-
-
-